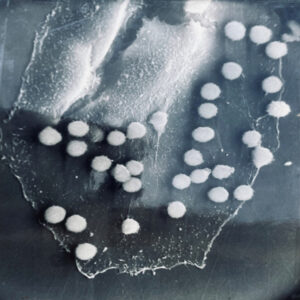

Dr. Patrick Herbert Cleveland, a scientist, professor and entrepreneur from Shelby, MT is the co-founder (with CFO wife Victoria) and President & CEO of V&P Scientific, Inc. where he has invented and produced over 2,000 scientific tools and mixing machines for the life sciences. He has 15 patents and is still inventing at age 81. He has indeed lived the American Dream. He lives in Rancho Santa Fe, CA and received the 2019 Montana State University College of Letters and Sciences Distinguished Alumni Award.

I spent most of my young life in Montana traveling with my heavy equipment operating father and my elementary school teacher mother going from one construction job to the next Townsend (where my grandparents had a farm/ranch), Fort Harrison, Helena, Terry, Tiber Dam, Shelby and Stanford. We settled in Shelby long enough for my older brother Mike and I to finish high school. I was a B student who was more interested in sports, hunting, having fun and girls in that order. I threw wild parties whenever my parents left town, I wrecked (totaled) my mother’s car drag racing up Main Street. I never really applied myself in school. Other than PE the only A I got in high school was in Biology (taught by the only teacher I respected, my coach Don Driscoll). My parents told me that I wasn’t college material and sent me to an electronic trade school in Denver after high school, I got decent grades but still couldn’t find a job in electronics other than radio and TV repair in the back end of a dusty old shop. So the next winter after a series of really dirty jobs, I worked as a laborer, wading in knee deep ice water and pumping the water out of the core trench of the Dillon Colorado Dam. The absolute coldest job in the world.
That spring my father was able to get me job as an oiler on a crane that was digging the Minute Man Missile silos near Stanford MT and I came back to Montana. After working on the Missiles for 6 months and gaining some much-needed maturity I decided that life had more to offer than just drinking beer and cussing, so I applied and was accepted at MSC Winter quarter of 1962. I took Microbiology 101 and was hooked. I would work for 6 months and go to MSC for 6 months until I got smart and married my friend from Shelby, Vicky Stene 12/29/62. Vicky dropped out of MSC and started working on her PHT degree (Putting Hubby Through)

I graduated with my BS in Microbiology from MSU in 1966 just hours before my mother graduated from Western Montana College in Dillon with her BA in education, so I won the bragging rights as the first in my family to graduate college.
MSU launched my career as a scientist, gave me a purpose in life and I am ever mindful of the important role the faculty and MSU played in my development of critical thinking and problem-solving abilities.

After graduating with my Masters in Virology, I went to the “Dark Side” and accepted a position as an Electron Microscopist for Dow Chemical. The “elite academicians” said that only the worst scientists worked in industrial firms or even pharmaceutical companies. Dow’s labs were very well equipped with the latest equipment and best supplies – I no longer had to waste time washing my own pipets and glassware – everything was new and disposable. I met my first true genius there and I was allowed to design my own experiments and pursue my ideas. I learned that all the bad stories about working in the industry were untrue.
My department bought the second scanning electron microscope (SEM) sold in the USA (first one went to Harvard). SEM looks at the surface of structures and no one had yet figured out how to preserve soft biological tissues in their natural state once the water was removed. I devised the first way to preserve the surface structure of mammalian retinas so the interaction of cellular processes between different cellular layers could be easily distinguished and followed. Dow saw that my project had great PR value (this was the time period that Dow was making and selling napalm to the military in Vietnam). Dow sent me to many scientific meetings to show that Dow also did good scientific research.
After 2 years at Dow I applied and was accepted into a Ph.D. program in the Department of Microbiology at the University of Minnesota where I did research in tumor immunology and discovered that mouse tumors expressed antigens identical to antigens present on fetal cells and that female mice that have had several litters of babies had high levels of antibodies to these fetal antigens. Others have followed up on my studies on fetal antigens using human tumors and they developed the current carcinoembryonic antigen test (CEA) used to monitor cancer patients for the presence or recurrence of cancer.

As I was leaving Minnesota with my Ph.D. I developed and later patented the first 96 well filter manifold for trapping tumor cells on the filters and perfected the first diagnostic assay for tumor antigens using filter trapped tumor cells. This filtration assay method greatly sped up the assay process and facilitated the washing of the filtered material. Filter assays could be used to detect and quantitate both soluble antigens, cell associated antigens, and antibodies or other ligands. Filter methodology was a significant improvement in rapid diagnostic assays and has been widely adopted in many scientific fields.
I took this new filtration assay method to the University of California San Diego and perfected it over the next 2 years in the Department of Surgery using human tumor cells. I then joined the Department of Ophthalmology at UCSD working with Dr. David Worthen. He remembered my work at Dow and offered me a position in his laboratory. He encouraged me to apply for a patent on the filter manifold and I did in 1978 and it was finally granted in 1984. I also applied for and received National Eye Institutes grants to develop rapid diagnostic filter assay methods to detect viral antigens in eye swabs. I collaborated with UCSD Infectious disease investigators to develop rapid diagnostic filter assay methods to detect viral, bacterial, and chlamydial antigens in genital swabs.
I made a slight modification of the filter manifold design which allows for a sheet of the membrane to be sandwiched between an incubation chamber and a vacuum chamber. This modification of the original design is used in genetic DNA and RNA hybridization assay methods that launched the genetic revolution of the 1980’s.
Vicky and I started V&P Enterprises in our garage in 1978 using money from an inheritance Vicky had received. It was a 2-person company, I was the production manager and Vicky was the CFO. We made the filter manifolds by hand (our hands). Our first sale other than to my lab was to the first monoclonal antibody company, Hybritech, which was founded by Dr. Ivor Royston a friend and research colleague. Hybritech modified the filter design and made the first urine pregnancy test called the ICON. The ICON was the first profitable product Hybritech launched. It generated $30,000,000 over a 3-year period.
Ivor and I were viewed suspiciously by our academic colleagues at UCSD. Many of our academic colleagues felt it was improper for a faculty member to profit from inventions that resulted from government funded research. Both Ivor and I had made our inventions on our own time and with our own funding but because we were both in the School of Medicine at UCSD, the Dean decided to set up special “Conflict of Interest Committees” for each inventor who had commercial companies outside the university in an effort to provide a mechanism to encourage us to stay at the university and still transfer our technology to the private world without taking inappropriate advantage of the situation. This system worked because 1) The key to introducing a new invention to market, is the exclusivity of the right to own the commercialization. 2) A patent is the motor that drives the commercialization process. 3) The inventor’s ego is the energy that pushes commercialization forward. 4) Money is the oil that makes commercialization go faster.
Ivor got venture capital money to start Hybritech and offered me the job as head of research which I turned down so I could grow V&P organically – no venture capital money. I sometimes wonder what would have happened if I had taken the other fork in the road, but only for about 5 seconds. It is better to be the driver of your own destiny than a cog in a large machine

I continued my research using the filter manifold technique to diagnose Cancer, Viruses, Bacteria, and Soluble Antigens and Antibodies at UCSD while nurturing V&P through its early development. I made several new patentable inventions that the UC patent office failed to process properly. I was so angry I wrote a 16 page letter to the President of the University of California system that detailed what was wrong with the current Technology Transfer system and what should be done to change it. I became involved in the effort to revise and revamp the UC Technology Transfer process system wide. With a $500,000 grant UCSD got from the Hartford Foundation, myself and other faculty and UCSD staff studied and made proposals to improve the Technology Transfer process. The proposals our group recommended were implemented at all 9 UC campuses as well as Lawrence Livermore National Labs and Los Alamos laboratory. Those changes unleashed the entrepreneurial energy of scientists in the UC system and has launched hundreds of new companies and hundreds of thousands of new jobs. It is an example of what can be done to effect change instead of just bitching about a bad system.

In the 1990’s I got involved in the research community’s effort to speak out against the animal rights movement. I became a spokesman for UCSD’s use of animals in research and the President of a group defending the right of scientists to use animals in research. We would explain to the public and teachers why it was necessary to use animals in research and the safeguards that scientists institute to prevent suffering. It was a challenging time and I received hate mail and death threats from the local animal rights group. Despite these problems, we were able to prevent animal rights literature from being incorporated into the California K through 12 school curricula. I authored a paper about the animal rights movement’s efforts and methods to infiltrate their message into the schools of this country. That paper even though it was first written in 1994, is still circulating and has been reposted on many websites and it is still relevant today as the struggle goes on. The California Biomedical Research Association gave me an award for my work defending the use of animals in research. Nice to be acknowledged for what we accomplished, but it is a never-ending battle against a new religion that will not go away. 1993 was a time for me to retire from that battlefield and pursue a more productive path for my family.

I took an early retirement from UCSD in 1993 (age 51) and put all my efforts into building up V&P as a business that would make tools and mixing machines for scientists.

I had an invention in this time period called the Multi-Blot Replicator (if used manually) or a Pin Tool (if used on Robotic liquid handler) which allowed scientists to both replicate 96, 384 or 1,536 microplates and transfer small volumes of liquid, microbial or genetic libraries contained in hundreds of thousands of wells in microplates, easily, economically and accurately. It was also a method to change the format from a 96 well plate to a 384 well plate to 1,536 well plate. This simple handheld devise came along at a time when genetic scientists were just beginning to start collecting, sharing and growing genomic libraries – perfect timing. We later modified the Pin Tool so it could be manipulated by a robotic liquid handler and perform screening assays on only nanoliter quantities of a drug. Mating over 30 different robotic liquid handlers with our Pin Tools, large pharmaceutical companies can routinely screen over 2,000,000 drugs in a single day. V&P has sold the Multi-Blot Replicators and the Robotic Pin Tools to academic labs, research institutions, biotech companies or pharmaceutical companies in most countries in the developed world. Our pin tools are capable of accurately delivering as little as 1 nanoliter of a drug (the size of a drop on the end of an acupuncture needle). Nearly every pharmaceutical company in the world buys our pin tools to screen their compound libraries for activity (activity like the ability to kill cancer cells).

My next patented invention was the Magnetic Vertical Tumble Stirrer which uniformly stirs all the wells of a hundred microplates at the same time by tumbling stir bars vertically instead of spinning them horizontally. It has thousands of different applications but the most popular one is to facilitate the parallel synthesis of new drugs by redox chemistry. Virtually every pharmaceutical company in the developed world has purchased one of our Vertical Tumble Stirrers for this or other applications.

By standing a Vertical Tumble on its end and arranging the tubes, bottles or microplate around it, the stir elements are attracted to the lateral wall of the vessel and turn laterally end over end. Hence the term Lateral Tumble Stirrer

Celera Genomics approached me in 1998 to solve a problem they had with human DNA which had the consistency of snot in the bottom of tall tiny wells of a 384 deep well microplate so it needed to be uniformly mixed throughout the entire height of the well. My solution was to make a magnetic levitation stirrer that would raise and lower tiny special steel balls in the tall tiny wells and thus suspend the DNA so it could be read on the DNA sequencing machine (which was invented by another Montana scientist, Dr. Leroy Hood, also from Shelby).This turned out to be one of several “Enabling Technologies” that allowed Celera Genomics to sequence 5 different people while the NIH’s Human Genome Project and all the other genetic laboratories in the world collaborated to sequence only one person (Pieter de Jong). We patented and made several of these machines as well as machines to put the steel balls into the wells for Celera. The decoding or sequencing of the human genome was the largest single research project ever attempted and perhaps the most significant scientific accomplishment, as it has led to many new ways to prevent, diagnose, treat and cure disease. The findings of these studies are still being explored today.


The next advance in diagnostic assays was the use of magnetic beads with either antigen or antibody attached to them so the wash steps can be accomplished by simply placing a magnet near the well. V&P has made over 60 different magnetic separation devices to accommodate most of the microplates on the market and supplies them to diagnostic companies which sell them as part of their diagnostic kits.

The latest V&P invention is the SpinVessel® (Patented), which allows scientists to vortex, mix, stir, suspend, agitate, aliquot, and aerate without a stir bar in the vessel! This new system uses a newly designed spin vessel with internal fins that allows for efficient, yet gentle mixing by simply spinning the vessel and repeatedly changing the spin direction from clockwise to counterclockwise. This method has the advantage of a gentle mixing or suspending method that won’t damage fragile beads or delicate cells as the shear forces produced by a stir bar do. Popular SpinVessel applications include uniformly suspending particulates such as cells, beads, magnetic beads, resins, or organoids for sampling or aliquoting.

My gift from God is a subconscious brain that never sleeps and keeps working on solving problems even when I sleep and wakes me up at 3:00 am with the solution to a vexing problem. Many of the directions my life has taken me were guided by God.
The proudest accomplishment of my life is that I helped raise, nurture, and coach 3 great successful children along with my beautiful wife Vicky. Vicky and I formed a perfectly balanced partnership in our approach to raising the children. I couldn’t have done it or V&P without her.
Lauri, the oldest and best natural athlete of the 3, who could throw a football 60 yards and played second base on the boy’s team, decided to take up tennis in high school. After high school, she went to UCSD and graduated in Economics and then went to the University of Chicago and graduated with an MBA. She learned to golf and had a successful career as an Investment Banker on Wall Street at Merrill Lynch and Lehman Brothers. She is married to a successful Investment Banker and together they form an investment banking brain trust. She is also the mother of two sons and is a champion golfer.
Greg, was his high school’s Scholar Athlete and 3 sport letterman. Although not a natural athlete he made up for that with determination and desire and was nominated to the all-county football team. He was selected for the US Military Academy (West Point) and he played on the football and powerlifting teams. He was a key member of the offensive line that set NCAA records in rushing yards his senior year. He also received an award as the best Spanish Speaker at West Point. Greg also received an MBA while stationed at Fort Sill, OK. After military service in Germany and Macedonia, he took a job as a Project Engineer in the power and energy division of General Electric. He has traveled all over the USA and the world installing power plants and wind turbines. Greg is the father of twin sons and a “total package” daughter.
Amy was also a 3 sport letterman and should have been her high school’s Scholar Athlete, but I had a dispute with one of the coaches and he took it out on her (sorry Amy). Amy also demonstrated the determination and desire to work and perfected her basketball skills. She led her high school team to a league championship, and she was nominated to the all-county basketball team. She was recruited to play basketball at Claremont McKenna College and was a 4 year starter on the basketball team. She set over 25 scoring records over her career and was nominated to the all-conference team all 4 years. Her senior year she led the team to the NCAA playoff games. She graduated from Claremont McKenna and played professional basketball in Germany for 2 years leading her team in scoring the first year. Amy is now operating a very successful club sports program in the largest basketball arena in San Diego County (7 courts in one facility and recently added 5 courts in another facility). In 2014 Amy was inducted into the Claremont McKenna Sports Hall of Fame with 19 of her records still standing.

“Scientists aren’t famous. They never endorse products or sign autographs or fight through crowds of screaming admirers. But at least you know a few of their names, like Jonas Salk, the developer of the polio vaccine; or Albert Schweitzer, the missionary who built hospitals in Africa…. But I’d bet not one of you knows the name of the scientist who saved more lives than all other scientists combined —1…..
Maurice Hilleman was from Miles City Montana graduated first in his class in Chemistry and Microbiology at Montana State College in 1941 and went on to develop over 60 vaccines and is credited with saving nearly a billion lives no one knows his name because the Nobel Prize committee does not give prizes to scientists that work for companies like Merck. Maurice was one of Patrick’s heroes when he attended MSC and he hopes that new MSU students will also be inspired by Maurice’s story. See Vaccinated – One Man’s Quest to Defeat the World’s Deadliest Diseases by Paul A Offit.
| Pin | Description | nl Transferred | CV% | |
|---|---|---|---|---|
| 0.229 mm diameter (FP9) | Total Pin | Uncoated | 7.41 | 2.4 |
| Hydrophobic | 7.46 | 5.4 | ||
| 0.229 mm diameter (FP9) | Hanging Drop | Uncoated | N/A | N/A |
| Hydrophobic | 2.09 | 3.8 | ||
| 0.457 mm diameter (FP1) | Total Pin | Uncoated | 33.48 | 3.2 |
| Hydrophobic | 28.17 | 7.5 | ||
| 0.457 mm diameter (FP1) | Hanging Drop | Uncoated | 16.96 | 4.5 |
| Hydrophobic | 8.51 | 0.8 | ||
| 0.787 mm diameter (FP3) | Total Pin | Uncoated | 87.32 | 3.9 |
| Hydrophobic | 77.4 | 3.9 | ||
| 0.787 mm diameter (FP3) | Hanging Drop | Uncoated | 48.77 | 1.2 |
| Hydrophobic | 43.05 | 9.4 | ||
| 1.19 mm diameter (VP 409 & VP 386) | Total Pin | Uncoated | 247.22 | 2.8 |
| Hydrophobic | 192.67 | 2.6 | ||
| 1.19 mm diameter (VP 409 & VP 386) | Hanging Drop | Uncoated | 76.35 | 1.6 |
| Hydrophobic | 108.4 | 2.8 | ||
| 1.58 mm diameter (VP 408 & VP 384) | Total Pin | Uncoated | 273.5 | 4.6 |
| Hydrophobic | 259.25 | 3.1 | ||
| 1.58 mm diameter (VP 408 & VP 384) | Hanging Drop | Uncoated | 201.93 | 5 |
| Hydrophobic | 170.04 | 7.5 |
Transfer Of Horseradish Peroxidase In Tris Buffered Saline With Pin Tools
Coating pins will reduce the total amount of liquid transferred and also reduce the amount of non-specific binding to the stainless-steel pins. If the substance you are transferring has high non-specific binding this will be an important factor in selecting your pins.
| Pin | Description | nl Transferred | CV% | |
|---|---|---|---|---|
| 0.229 mm diameter (FP9) | Total Pin | Uncoated | 7.41 | 2.4 |
| Hydrophobic | 7.46 | 5.4 | ||
| 0.229 mm diameter (FP9) | Hanging Drop | Uncoated | N/A | N/A |
| Hydrophobic | 2.09 | 3.8 | ||
| 0.457 mm diameter (FP1) | Total Pin | Uncoated | 33.48 | 3.2 |
| Hydrophobic | 28.17 | 7.5 | ||
| 0.457 mm diameter (FP1) | Hanging Drop | Uncoated | 16.96 | 4.5 |
| Hydrophobic | 8.51 | 0.8 | ||
| 0.787 mm diameter (FP3) | Total Pin | Uncoated | 87.32 | 3.9 |
| Hydrophobic | 77.4 | 3.9 | ||
| 0.787 mm diameter (FP3) | Hanging Drop | Uncoated | 48.77 | 1.2 |
| Hydrophobic | 43.05 | 9.4 | ||
| 1.19 mm diameter (VP 409 & VP 386) | Total Pin | Uncoated | 247.22 | 2.8 |
| Hydrophobic | 192.67 | 2.6 | ||
| 1.19 mm diameter (VP 409 & VP 386) | Hanging Drop | Uncoated | 76.35 | 1.6 |
| Hydrophobic | 108.4 | 2.8 | ||
| 1.58 mm diameter (VP 408 & VP 384) | Total Pin | Uncoated | 273.5 | 4.6 |
| Hydrophobic | 259.25 | 3.1 | ||
| 1.58 mm diameter (VP 408 & VP 384) | Hanging Drop | Uncoated | 201.93 | 5 |
| Hydrophobic | 170.04 | 7.5 |
Transfer Of Horseradish Peroxidase In Tris Buffered Saline With Pin Tools
Although the slots in the pin are a precise volume, the liquid that is transferred is usually more. The reason for this is due to the surface tension of the liquid causing the liquid in the slot to “bow out” thus increasing the volume of the liquid in the slot. If is important for you to transfer exactly a certain volume we can make custom slots to match the surface tension characteristics of your liquid
| Solvent/Sample | Concentration | CV% | nl FITC Transferred | CV% | nl FITC Transferred |
|---|---|---|---|---|---|
| Uncoated | Uncoated | Hydrophobic Coated | Hydrophobic Coated | ||
| DMSO (-) | 0 | 8.1 | 353.42 | 7.5 | 298.72 |
| DMSO + DNA (mg/ml) | 0.5 | 6.6 | 497.21 | 6.6 | 435.86 |
| 0.25 | 9 | 432.49 | 4.1 | 391.93 | |
| 0.125 | 8.9 | 363.64 | 0.9 | 344.75 | |
| 0.0625 | 2.3 | 381.86 | 2 | 331.68 | |
| 0.0313 | 1.5 | 378.03 | 4.4 | 331.71 | |
| 0.0156 | 1.2 | 357.52 | 1.4 | 329.03 | |
| Tris (-) | 0 | 4.9 | 577.31 | 7.2 | 493.53 |
| Tris + DNA (mg/ml) | 0.5 | 4.5 | 540.53 | 1.1 | 477.5 |
| 0.25 | 4.6 | 518.21 | 6.1 | 456.75 | |
| 0.125 | 15.8 | 583.25 | 4.1 | 438.82 | |
| 0.0625 | 4.2 | 551.17 | 3.1 | 433.69 | |
| 0.0313 | 4.4 | 536.66 | 2.3 | 458.37 | |
| 0.0156 | 2.9 | 528.53 | 1.2 | 441.1 | |
| Tris + BSA (%) | 4 | 5.4 | 462.13 | 11 | 409.27 |
| 1 | 4 | 452.86 | 2.7 | 426.58 | |
| 0.25 | 11.7 | 456.45 | 1.3 | 408.72 | |
| 0.0625 | 1.1 | 445.22 | 6.5 | 393.07 | |
| 0.0156 | 3.7 | 462.85 | 3.9 | 430.2 | |
| 0.0039 | 1.5 | 493.54 | 2.2 | 437.29 | |
| 0.001 | 2.9 | 504.25 | 0.7 | 475.96 |
1. Increasing the concentration of DNA (sheared salmon sperm) to .25 mg/ml significantly increases the volume of DMSO liquid transferred for both coated and uncoated FP3S500 Slot Pins.
2. Increasing the concentration of DNA does not significantly increase the volume of Tris buffer (aqueous) transferred by both coated and uncoated FP3S500 Slot Pins.
3. Increasing the concentration of BSA (Bovine Serum Albumin) significantly decreases the volume of Tris buffer transferred by both coated and uncoated FP3S500 Slot Pins.
4. Hydrophobic coated FP3S500 Slot Pins transferred less DMSO – DNA and less Tris DNA and less Tris BSA than the uncoated FP3S500 Slot Pins.
5. Both coated and uncoated FP3S500 pins transfer significantly more aqueous solution than DMSO.
| Solvent/Sample | Concentration | CV% | nl FITC Transferred | CV% | nl FITC Transferred |
|---|---|---|---|---|---|
| Uncoated | Uncoated | Hydrophobic Coated | Hydrophobic Coated | ||
| DMSO (-) | 0 | 4.2 | 49.38 | 2.1 | 49.31 |
| DMSO + DNA (mg/ml) | 0.5 | 4.9 | 51.24 | 2.6 | 56.79 |
| 0.25 | 1.7 | 50.2 | 1.2 | 49.53 | |
| 0.125 | 1.5 | 51.27 | 2.3 | 49.77 | |
| 0.0625 | 2.2 | 49.34 | 4.1 | 48.19 | |
| 0.0313 | 1.2 | 49.03 | 0.2 | 50.23 | |
| 0.0156 | 2.4 | 45.9 | 1.4 | 46.64 | |
| Tris (-) | 0 | 2.6 | 89.51 | 2.9 | 91.34 |
| Tris + DNA (mg/ml) | 0.5 | 7 | 77.11 | 0.6 | 84.62 |
| 0.25 | 3.9 | 82.22 | 1.6 | 84.89 | |
| 0.125 | 3.9 | 85.42 | 1 | 85.08 | |
| 0.0625 | 1.5 | 85.36 | 2.8 | 85.03 | |
| 0.0313 | 2 | 84.52 | 3 | 88.19 | |
| 0.0156 | 2.6 | 82.92 | 2.8 | 83.2 |
1. In contrast to the FP3S500 data, increasing the concentration of DNA to .25 mg/ml does not significantly increase the volume of DMSO liquid transferred for both coated and uncoated FP1S50 Slot Pins.
2. Increasing the concentration of DNA does not significantly increase the volume of Tris buffer (aqueous) transferred by both coated and uncoated FP1S50 Slot Pins.
3. In contrast to the FP3S500 data, FP1S50 coated pins transferred about the same volume of DNA at all concentrations as did uncoated pins.
4. Both coated and uncoated FP1S50 pins transfer significantly more aqueous solution than DMSO.
5. The differences between the FP3S500 and the FP1S50 pin may be due to the different pin diameter’s effect on contact angle and therefore on the “wetting” of the pin. See the diagram on the link to / ah energy system.
| Pin | Description | nl Transferred | CV% | |
|---|---|---|---|---|
| 0.229 mm diameter (FP9) | Total Pin | Uncoated | 7.41 | 2.4 |
| Hydrophobic | 7.46 | 5.4 | ||
| 0.229 mm diameter (FP9) | Hanging Drop | Uncoated | N/A | N/A |
| Hydrophobic | 2.09 | 3.8 | ||
| 0.457 mm diameter (FP1) | Total Pin | Uncoated | 33.48 | 3.2 |
| Hydrophobic | 28.17 | 7.5 | ||
| 0.457 mm diameter (FP1) | Hanging Drop | Uncoated | 16.96 | 4.5 |
| Hydrophobic | 8.51 | 0.8 | ||
| 0.787 mm diameter (FP3) | Total Pin | Uncoated | 87.32 | 3.9 |
| Hydrophobic | 77.4 | 3.9 | ||
| 0.787 mm diameter (FP3) | Hanging Drop | Uncoated | 48.77 | 1.2 |
| Hydrophobic | 43.05 | 9.4 | ||
| 1.19 mm diameter (VP 409 & VP 386) | Total Pin | Uncoated | 247.22 | 2.8 |
| Hydrophobic | 192.67 | 2.6 | ||
| 1.19 mm diameter (VP 409 & VP 386) | Hanging Drop | Uncoated | 76.35 | 1.6 |
| Hydrophobic | 108.4 | 2.8 | ||
| 1.58 mm diameter (VP 408 & VP 384) | Total Pin | Uncoated | 273.5 | 4.6 |
| Hydrophobic | 259.25 | 3.1 | ||
| 1.58 mm diameter (VP 408 & VP 384) | Hanging Drop | Uncoated | 201.93 | 5 |
| Hydrophobic | 170.04 | 7.5 |
Hydrophobic coating pins will reduce the total amount of aqueous HRP liquid transferred and also reduce the amount of non-specific binding to the stainless-steel pins. If the substance you are transferring has high non-specific binding this will be an important factor in selecting your pins.
Pin diameter also has an effect on the degree of reduction of liquid transfer with hydrophobic coating as the smaller the diameter the less the reduction of transfer. This is most likely due to the curvature of the pin affecting the wetting contact angle
| Pin | Description | nl Transferred | CV% | ||
|---|---|---|---|---|---|
| 0.457 mm diameter (FP1) | 6 nl Slot | Total Pin* | Uncoated | 25.6 | 10.8 |
| Hydrophobic | N/A | N/A | |||
| 10 nl Slot | Total Pin* | Uncoated | 23.36 | 6.1 | |
| Hydrophobic | 25.85 | 6.9 | |||
| 50 nl Slot | Total Pin* | Uncoated | 67.83 | 2.5 | |
| Hydrophobic | N/A | N/A | |||
| 0.787 mm diameter (FP3) | 100 nl Slot | Total Pin* | Uncoated | 180.32 | 7.2 |
| Hydrophobic | 205.84 | 5.5 | |||
| 200 nl Slot | Total Pin* | Uncoated | 277.82 | 4.9 | |
| Hydrophobic | 287.3 | 3.8 | |||
| 500 nl Slot | Total Pin* | Uncoated | 581.16 | 5.2 | |
| Hydrophobic | 555.69 | 3 |
Hydrophobic coating pins will slightly increase the total amount of DMSO FITC liquid transferred.
| Pin | Description | nl Transferred | CV% | |
|---|---|---|---|---|
| 0.787 mm diameter (FP3) | 100 nl Slot Total Pin, Including Slot | Uncoated | 195.69 | 1.6 |
| Hydrophobic | 170.2 | 2.9 | ||
| 0.787 mm diameter (FP3) | 100 nl Slot, Slot Only | Uncoated | 149.67 | 4.9 |
| Hydrophobic | 129.61 | 7.6 | ||
| 0.787 mm diameter (FP3) | 200 nl Slot Total Pin, Including Slot | Uncoated | 269.77 | 1.9 |
| Hydrophobic | 228.62 | 17.1 | ||
| 0.787 mm diameter (FP3) | 200 nl Slot, Slot Only | Uncoated | 237.52 | 8.9 |
| Hydrophobic | 186.9 | 5.9 |
Although the slots in the pin are a precise volume, the liquid that is transferred is usually more because of the volume carried on the sides of the pins.
As seen with other aqueous data the amount transferred on hydrophobic coated Slot pins is less than on uncoated Solid or Slot pins. Thus Hydrophobic coating has the most effect on aqueous transfers.
Note: Same volume (200ul for 96 Format and 74 ul for 384 Format) in recipient plates and same pin withdrawal speed for all pins. Changes to pin withdrawal speed or volume in the source plate can result in different volumes being transferred.
Transfer volumes should always be confirmed by customers for their assay conditions and automated system.
| Pin Type | Pin Diameter(mm) | Shape | 96 Format Low Range(nL)² | 96 Format High Range(nL)² |
|---|---|---|---|---|
| FP9 | 0.229 | Solid | 13 | 39 |
| FP8 | 0.356 | Solid | 15 | 37 |
| FP1 | 0.457 | Solid | 22 | 61 |
| FP1S6 | 0.457 | 6nL Slot | 34 | 67 |
| FP1S10 | 0.457 | 10nL Slot | 39 | 74 |
| FP1S50 | 0.457 | 50nL Slot | 90 | 124 |
| FP3 | 0.787 | Solid | 93 | 213 |
| FP3S100 | 0.787 | 100nL Slot | 213 | 334 |
| FP3S200 | 0.787 | 200nL Slot | 311 | 449 |
| FP3S500 | 0.787 | 500nL Slot | 515 | 671 |
| FP4 | 0.914 | Solid | 126 | 289 |
| Footnotes: (1) Delivery volume range is determined by speed of withdrawal from source liquid: Z-Speed Range = 1.5-30 mm/sec, slow speed = low volume delivery range, fast speed = high volume delivery range (2) 200ul source plate volume per well | ||||
| Pin Type | Pin Diameter(mm) | Shape | 96 Format Low Range(nL)² | 96 Format High Range(nL)² |
|---|---|---|---|---|
| FP9 | 0.229 | Solid | 13 | 38 |
| FP8 | 0.356 | Solid | ||
| FP1 | 0.457 | Solid | 23 | 60 |
| FP1S6 | 0.457 | 6nL Slot | 33 | 67 |
| FP1S10 | 0.457 | 10nL Slot | 40 | 75 |
| FP1S50 | 0.457 | 50nL Slot | 86 | 119 |
| FP3 | 0.787 | Solid | 76 | 209 |
| FP3S100 | 0.787 | 100nL Slot | 188 | 324 |
| FP3S200 | 0.787 | 200nL Slot | 288 | 436 |
| FP3S500 | 0.787 | 500nL Slot | 473 | 649 |
| FP4 | 0.914 | Solid | ||
| Footnotes: (1) Delivery volume range is determined by speed of withdrawal from source liquid: Z-Speed Range = 1.5-30 mm/sec, slow speed = low volume delivery range, fast speed = high volume delivery range (2) 200ul source plate volume per well | ||||
| Pin Type | Pin Diameter(mm) | Shape | Low Range(nL)² | High Range(nL)² |
|---|---|---|---|---|
| FP | 1.58 | Solid Pointed | 175 | 594 |
| FPS.5 | 1.58 | 500nL Slot | 524 | 962 |
| FPS | 1.58 | 1000nL Slot | 1056 | 1476 |
| FPS2 | 1.58 | 2000nL Slot | 1739 | 2174 |
| FPS5 | 1.58 | 5000nL Slot | 5150 | 4953 |
| FP6 | 1.58 | Solid Flat | 465 | 960 |
| FP6S.5 | 1.58 | 500nL Slot | 934 | 1445 |
| FP6S | 1.58 | 1000nL Slot | 1396 | 1930 |
| FP6S2 | 1.58 | 2000nL Slot | 2072 | 2637 |
| FP6S5 | 1.58 | 5000nL Slot | 4820 | 4693 |
| Footnotes:(1) Delivery volume range is determined by speed of withdrawal from source liquid: Z-Speed Range = 1.5-30 mm/sec, slow speed = low volume delivery range, fast speed = high volume delivery range (2) 200ul source plate volume per well for 96 Format and 75ul source plate volume per well for 384 Format |
||||
| Pin Type | Pin Diameter(mm) | Shape | 96 Format Low Range(nL)² | 96 Format High Range(nL)² | 384 Format Low Range(nL)³ | 384 Format High Range(nL)³ |
|---|---|---|---|---|---|---|
| FP9 | 0.229 | Solid | 4 | 10 | 3 | 8 |
| FP8 | 0.35 | Solid | 13 | 26 | 6 | 18 |
| FP1 | 0.457 | Solid | 18 | 43 | 11 | 31 |
| FP1S6 | 0.457 | 6nL Slot | 24 | 49 | 15 | 34 |
| FP1S10 | 0.457 | 10nL Slot | 30 | 54 | 21 | 40 |
| FP1S20 | 0.457 | 20nL Slot | 37 | 61 | 27 | 46 |
| FP1S30 | 0.457 | 30nL Slot | 46 | 68 | 35 | 54 |
| FP1S40 | 0.457 | 40nL Slot | 57 | 78 | 45 | 63 |
| FP1S50 | 0.457 | 50nL Slot | 70 | 90 | 56 | 75 |
| FP3 | 0.787 | Solid | 67 | 139 | 29 | 79 |
| FP4 | 0.91 | Solid | 94 | 197 | 34 | 98 |
| FP3S100 | 0.787 | 100nL Slot | 175 | 241 | 114 | 163 |
| FP3S200 | 0.787 | 200nL Slot | 280 | 332 | 203 | 250 |
| FP3S500 | 0.787 | 500nL Slot | 535 | 559 | 427 | 464 |
| FP4S1000 | 0.91 | 1000nL Slot | 940 | 1011 | 704 | 800 |
| FP4S2000 | 0.91 | 2000nL Slot | 1518 | 1608 | 1277 | 1362 |
| Footnotes: (1) Delivery volume range is determined by speed of withdrawal from source liquid: Z-Speed Range = 1.5-30 mm/sec, slow speed = low volume delivery range, fast speed = high volume delivery range (2) 200ul source plate volume per well (3) 75ul source plate volume per well | ||||||
| Pin Type | Pin Diameter (mm) | Shape | 96 Format Low Range(nL)² | 96 Format High Range(nL)² | 384 Format Low Range(nL)³ | 384 Format High Range(nL)³ |
|---|---|---|---|---|---|---|
| FP9H | 0.229 | Solid | 4 | 10 | 3 | 8 |
| FP8H | 0.35 | Solid | 9 | 24 | 6 | 17 |
| FP1H | 0.457 | Solid | 15 | 39 | 9 | 27 |
| FP1S6H | 0.457 | 6nL Slot | 23 | 49 | 14 | 32 |
| FP1S10H | 0.457 | 10nL Slot | 29 | 53 | 20 | 38 |
| FP1S20H | 0.457 | 20nL Slot | 35 | 59 | 26 | 43 |
| FP1S30H | 0.457 | 30nL Slot | 47 | 69 | 35 | 53 |
| FP1S40H | 0.457 | 40nL Slot | 54 | 75 | 41 | 58 |
| FP1S50H | 0.457 | 50nL Slot | 69 | 90 | 57 | 73 |
| FP3H | 0.787 | Solid | 67 | 134 | 27 | 76 |
| FP4H | 0.91 | Solid | 95 | 189 | 32 | 102 |
| FP3S100H | 0.787 | 100nL Slot | 170 | 227 | 108 | 164 |
| FP3S200H | 0.787 | 200nL Slot | 266 | 320 | 190 | 239 |
| FP3S500H | 0.787 | 500nL Slot | 520 | 542 | 416 | 456 |
| FP4S1000H | 0.91 | 1000nL Slot | 932 | 1000 | 741 | 805 |
| FP4S2000H | 0.91 | 2000nL Slot | 1571 | 1638 | 1351 | 1423 |
| Footnotes: (1) Delivery volume range is determined by speed of withdrawal from source liquid: Z-Speed Range = 1.5-30 mm/sec, slow speed = low volume delivery range, fast speed = high volume delivery range (2) 200ul source plate volume per well (3) 75ul source plate volume per well | ||||||
| Pin Type | Diameter (mm) | Shape | 96 Format Low Range(nL)² | 96 Format High Range(nL)² | 384 Format Low Range(nL)³ | 384 Format High Range(nL)³ |
|---|---|---|---|---|---|---|
| FP | 1.58 | Solid Pointed | 147 | 411 | 168 | 395 |
| FPS.5 | 1.58 | 500nL Slot | 442 | 704 | 631 | 843 |
| FPS | 1.58 | 1000nL Slot | 893 | 1130 | 1343 | 1498 |
| FPS2 | 1.58 | 2000nL Slot | 1911 | 2038 | 2607 | 2767 |
| FPS5 | 1.58 | 5000nL Slot | 3908 | 4296 | 5180 | 5253 |
| FP6 | 1.58 | Solid Flat | 323 | 674 | 154 | 398 |
| FP6S.5 | 1.58 | 500nL Slot | 734 | 1042 | 855 | 1053 |
| FP6S | 1.58 | 1000nL Slot | 1210 | 1500 | 1638 | 1717 |
| FP6S2 | 1.58 | 2000nL Slot | 2299 | 2384 | 2787 | 3068 |
| FP6S5 | 1.58 | 5000nL Slot | 4329 | 4656 | 5237 | 5245 |
| Footnotes:(1) Delivery volume range is determined by speed of withdrawal from source liquid: Z-Speed Range = 1.5-30 mm/sec, slow speed = low volume delivery range, fast speed = high volume delivery range (2) 200ul source plate volume per well (3) 75ul source plate volume per well |
||||||